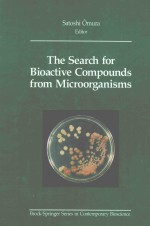
<em>The</em> Search <em>for</em> bioactive compounds from microorganisms

当前位置:首页 > FEEDBACK CONTROLLERS FOR THE PROCESS INDUSTRIES相关PDF电子书下载
-

-

Personal Computers for the Successful Small Business
DONALD HOCKNEY1984 年出版202 页ISBN:0025518704 -

ENERGY MANAGEMENT CHALLENGES FOR THE NEXT MILLENNIUM
PRADEEP CHATURVEDI2000 年出版240 页ISBN:8170228069 -

LEGAL PROTECTION FOR THE CONSUMER SECOND EDITION
STANLEY MORGANSTERN1978 年出版119 页ISBN:0379111179 -

-

MATERIALS TESTING FOR THE METAL FORMING INDUSTRY
KLAUS POHLANDT2222 年出版226 页ISBN:3540506519 -

SELLING DESTINATIONS GEOGAPHY FOR THE TRAVEL PROFESSIONAL
MARC MANCINI1994 年出版519 页ISBN:9780415492386 -
The Search for bioactive compounds from microorganisms
Satoshi Omura1992 年出版352 页ISBN:0387977554 -

-

THE INTERNET FOR DUMMIES 13TH EDITION
JOHN R.LEVINE AND MARGARET LEVINE YOUNG2012 年出版376 页ISBN:1118096147
